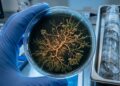
Micro-organismos congelados há 40 mil anos no permafrost do Alasca voltam à vida em laboratório e começam a devorar carbono ativamente

Imagine flutuar sobre vales profundos e tocar as nuvens enquanto o mundo lá fora parece uma pintura viva de neve e rocha. O Glacier Express oferece uma jornada emocional onde o tempo para, permitindo que cada passageiro sinta a grandiosidade dos Alpes Suíços em um silêncio quase sagrado.
Por que o Glacier Express é o trem expresso mais lento do mundo?
O canal Kuga’s Travel, com 493 mil inscritos, apresenta uma das experiências ferroviárias mais únicas do planeta. Diferente dos trens de alta velocidade, o Glacier Express foi projetado para a contemplação absoluta, percorrendo cerca de 290 quilômetros em oito horas para que nenhum detalhe das montanhas seja perdido.
Segundo dados técnicos da operadora Rhätische Bahn, a velocidade média é de apenas 36 km/h, transformando o trajeto em um verdadeiro mirante móvel. Essa lentidão é estratégica para vencer inclinações extremas e curvas fechadas que desafiam a gravidade em altitudes elevadas.
Como a engenharia do trem vence 291 pontes e 91 túneis?
Para atravessar o relevo hostil da Suíça, os engenheiros criaram uma malha ferroviária que parece ignorar as leis da física. O Glacier Express utiliza um sistema de cremalheira em trechos íngremes, onde engrenagens mordem os trilhos para escalar montanhas sem deslizar, sustentado por estruturas consideradas obras-primas da arquitetura mundial.
Os principais marcos de engenharia dessa rota são:
- Viaduto Landwasser, uma ponte curva de 65 metros que leva o trem diretamente para dentro de um túnel na rocha
- Passo de Oberalp, o ponto mais alto da linha, com incríveis 2.033 metros acima do nível do mar
- Desfiladeiro do Reno, conhecido como o “Grand Canyon da Suíça”, com formações geológicas milenares
Leia também: A ponte de concreto de 1898 que Harry Potter tornou famosa ainda recebe trens reais toda semana na Escócia
O que torna as janelas panorâmicas uma experiência única?
Os vagões do Glacier Express possuem janelas de vidro curvado que se estendem até o teto, eliminando barreiras visuais e permitindo observar o topo dos picos de 4.000 metros sem sair do assento. O design foi planejado para evitar reflexos, garantindo fotos perfeitas das geleiras e vilarejos ao longo do caminho.
Essa imersão visual une o conforto moderno à selvageria das paisagens alpinas, tornando cada minuto da viagem uma experiência que justifica cada segundo a bordo.

Quais são os serviços oferecidos a 2.000 metros de altitude?
O Glacier Express oferece serviços de luxo com refeições preparadas na hora dentro dos próprios vagões, enquanto o cenário alpino muda continuamente do lado de fora. O sistema de suspensão é ajustado para neutralizar as vibrações das engrenagens, proporcionando um deslizar suave mesmo nas subidas mais íngremes.
Confira os principais serviços exclusivos a bordo:

Essa combinação de conforto e imersão cultural transforma o Glacier Express em muito mais do que um simples meio de transporte nas montanhas.
Por que a rota entre Zermatt e St. Moritz é tão especial?
A linha conecta dois dos resorts de esqui mais luxuosos do mundo, Zermatt e St. Moritz, por um caminho que carros raramente conseguem acessar. Essa rota exclusiva revela áreas intocadas dos Alpes, onde o silêncio só é quebrado pelo suave som do trem sobre os trilhos de montanha.
É uma jornada que celebra a paciência, provando que o destino final importa menos do que a beleza encontrada no caminho mais lento da Terra.